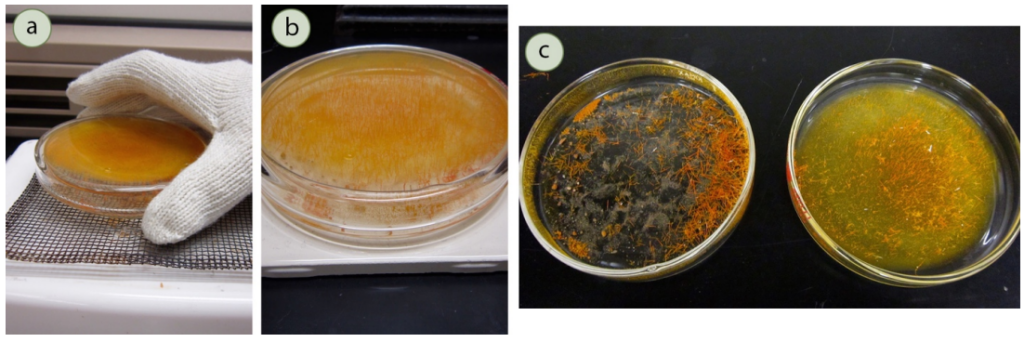

Sublimation Methods: A Complete Guide to Principles and Procedures
Overview
Sublimation is a unique phase transition where certain substances shift directly from a solid to a gaseous state, bypassing the liquid phase entirely. A classic example is solid carbon dioxide (commonly known as dry ice), which vaporizes into CO₂ gas under standard atmospheric pressure without becoming a liquid. This phenomenon is closely related to boiling but involves solid materials whose vapor pressure matches the surrounding pressure—often atmospheric. Unlike liquids, most solids do not possess significant vapor pressures at accessible temperatures, making sublimation methods applicable only to select compounds. These compounds usually exhibit weak intermolecular forces and often possess symmetrical molecular structures, such as DMT, TMA, or magnesium 4-hydroxybutyrate.

Why Use Sublimation Methods?
Sublimation techniques are widely employed for the purification of compounds. They offer several advantages, including:
- High selectivity due to a favorable separation coefficient
- Avoidance of solvent use, which is beneficial in gas-phase operations
- Lower thermal requirements compared to distillation
- Simple regulation of the deposition process
- Ability to directly obtain purified products in usable forms like thin films, crystals, or powders
- Production of high-purity materials and specialized composite structures
Vacuum Sublimation and Applicable Compounds
Since relatively few solids are suitable for sublimation, the process is particularly valuable when separating volatile substances from non-volatile contaminants. Typically, the impure solid is heated in a chamber near a cold surface—often a “cold finger.” As the volatile compound sublimes, it recondenses onto the cold finger, effectively separating it from residual impurities. However, sublimation methods are generally not effective at isolating one volatile solid from another.

Many sublimable substances require high temperatures to achieve adequate vapor pressure at atmospheric conditions. Unfortunately, some of these materials decompose or char when exposed to such heat. To overcome this, chemists often perform sublimation under reduced pressure, known as vacuum sublimation. This technique mirrors vacuum distillation but applies to solids—allowing them to sublime at lower temperatures, thus preserving compound integrity.
Sublimation Procedures at Atmospheric Pressure
The following procedure outlines the atmospheric sublimation of 0.29 grams of ferrocene, achieving approximately 90% recovery.

Sublimation Methods. Step-by-Step Instructions:
1. Preparation of Sample: Place the dry, impure solid in a thin layer on a lower petri dish. If the material is lumpy, grind it with a mortar and pestle. Ensure the top dish’s empty mass is recorded. Avoid wet samples to prevent unwanted condensation.
2. Assembly: Cover the bottom dish with the upper petri dish and place it on a wire mesh atop a hotplate (inside a fume hood). The mesh ensures even heat distribution and minimizes burning.
3. Cooling Setup: Position a 600 mL beaker filled with ice water on top of the upper dish to create a cold surface for crystal deposition.

4. Monitoring the Process: Watch the sample as it sublimes and collects on the top dish. If charring is observed, reduce the heat immediately. Continue heating until no solid remains on the bottom dish or sublimation ceases.
5. Post-Sublimation Handling: Carefully remove the dishes using thermal gloves or tongs. Let them cool on a ceramic tile in the fume hood without separating them immediately to avoid releasing vapors.
6. Crystal Recovery: After cooling, separate the dishes. Preserve the crystals formed on the top dish. If any clean, crystalline substance remains on the bottom, it may also be recovered.
Sublimation Methods. Sublimation Under Reduced Pressure (Vacuum Sublimation).
This method demonstrates the purification of camphor on two scales: 2.28 g (large scale) and 0.2 g (small scale), with about 77% recovery for the larger batch.

Sublimation Methods. Vacuum Sublimation Protocol:
1. Solid Preparation: If needed, grind the crude sample with a mortar and pestle. Transfer the dry material into the lower chamber of the sublimation apparatus.
2. Apparatus Setup: Secure the apparatus to a stand. Ensure proper support, especially for small-scale setups. Lightly grease the joints with silicone or vacuum grease to seal the system.
3. Vacuum Connection: Connect a vacuum source using thick rubber tubing. Make sure the system is leak-proof—hissing indicates poor sealing.

4. Cold Finger Cooling:
- If the cold finger has a condenser, circulate water through it.
- For simple cold fingers, fill with ice and water or a dry ice-acetone mix.
- Always apply vacuum before cooling to prevent premature condensation.
5. Heating the Sample: Use a heat gun or Bunsen burner, starting with low, gentle heat. Avoid sand baths or mantles, which heat too slowly or unevenly. Adjust heat as needed if sublimation doesn’t initiate.
6. Crystal Formation: As the compound sublimes, it condenses onto the cold finger and nearby surfaces. Gentle external heating can encourage deposition onto the cold finger instead of the walls.

7. Completion and Cooling: Continue until the lower section is fully depleted of volatile material. Reduce heat if the sample darkens to avoid thermal degradation.
8. Coolant Removal:
- Stop water flow or remove the coolant from the cold finger carefully.
- Use a pipette or baster to extract water if using an ice bath.
9. Repressurization: Let the apparatus reach room temperature. Slowly reintroduce atmospheric pressure to prevent dislodging the crystals.
10. Crystal Collection: Gently remove the cold finger and scrape off the purified crystals onto a watch glass. Alternatively, rinse them off with a solvent and collect them in a flask for further processing.

Conclusion
Sublimation methods offer a valuable and efficient approach for purifying volatile solids, especially those sensitive to heat or incompatible with traditional solvent-based purification. Whether performed under atmospheric or reduced pressure, sublimation enables the recovery of high-purity materials in various practical forms. When implemented with care, these techniques minimize decomposition, avoid solvent waste, and yield clean, ready-to-use chemical products.
Sources
- Hartmann, Heinz. “Notes on the theory of sublimation.” The psychoanalytic study of the child 10.1 (1955): 9-29. https://www.tandfonline.com/doi/pdf/10.1080/00797308.1955.11822547
- Civitarese, Giuseppe. “On sublimation.” The International Journal of Psychoanalysis 97.5 (2016): 1369-1392. https://www.tandfonline.com/doi/abs/10.1111/1745-8315.12530
- Arlow, Jacob A. “Sublimation.” Journal of the American Psychoanalytic Association 3.3 (1955): 515-527. https://journals.sagepub.com/doi/abs/10.1177/000306515500300309

